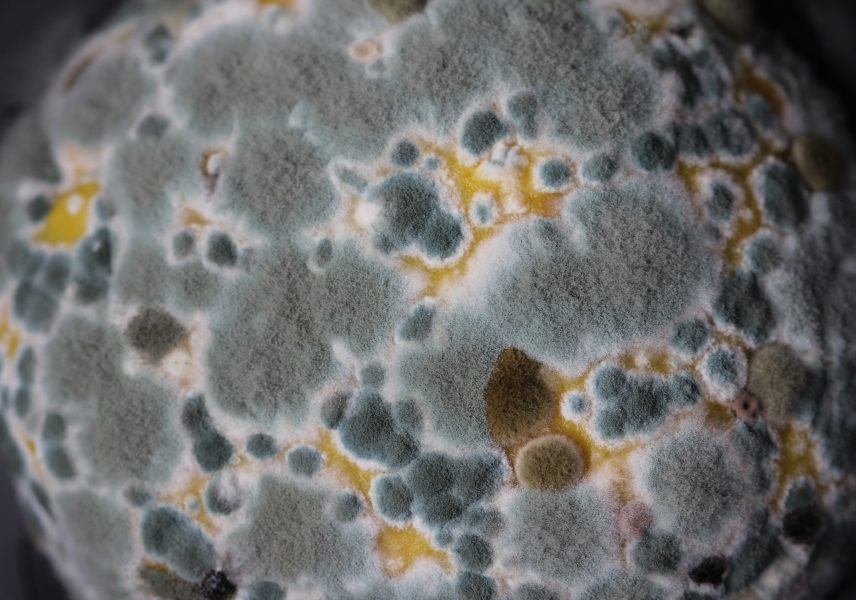

В наши дни достъпът до истинска и качествена храна е силно ограничен. В търговската мрежа човек трудно открива продкти, които да покриват неговите изисквания. Все по-често пазарът бива заливан с нови стоки с десетки изкуствени примеси, сред които се стоят и консервантите.
Но какво всъщност са консервантите и за кои от тях трябва да бъдем наясно и да ги избягваме, нека разберем сега.
Какво представляват консервантите?

Консервантите са вещества, които се изпозлват в хранителната промишленост. Всъщност консервантите представляват вещества, които имат за цел да поддържат продукта дълго време без той да търпи промяна. Промяната в случая, която иска да се избегне, е развалянето и/или разграждането на продукта вследствие някакви химични промени и/или развитие на микроби.
Друго наименование на консервантите е „подобрители“. Наричат ги така, защото те имат за цел да подобрят цвета, мириса и вкуса на храната.
Кои са онсовните типове консерванти?
- Антиоксиданти
- Антимикробни
- Аенти, предпазваши промяна в цвета на продукта
Има ли естествени консерванти?

В миналото, както сами се досещате, не са се изпозлвали днешните синтетични консерванти. Тогава хората са използвали естествени продукти от еженевието си. Такива се явяват медът, виното, солта, а по-късно са започнали да изпозлват оцета и алкохола.
Както сами се досешате, гореспоменантите „консерванти“ не носят това отрицателно значение, което ние днес влагаме в тази дума.
В наши дни, тези естествени консерванти се изпозлват за направата на нашата любима „зимнина“.
Е-тата
Много често се случва да говорим за така наречените Е-та и консервантите като едно и също нещо, но това определено е така.
Всъщност Е-тата представляват всички добавки в храните. В последствие те се делят на оцветители, сгъстители, регултори на киселиността, консерванти и тн. Като номерацията на консервантите се помещава от Е200 до Е299.
Кои са едни от най-опасните консерванти?

От Е210 до Е217 и Е240, Е249
Косервантите в номерацията между Е210 и Е217 са така наречените „канцерогенни“. Такива консерванти се намират най-вече в газираните и енергийните напитки и соковете.
Е210
Е210 представлява така наречената „бензоена киселина“. Него най-често можете да откриете в алкохолните напитки. Той е сред първенците по отношение степен на вреда върху организма. В комбинация с аскорбинова киселина (вит Ц) се образуват канцерогенни съединения.
От Е230 до Е233
Тези консерванти са известни с това, че след приема им могат да възникнат дразнения по кожата, а конкретно 233 води до покачване на телесното тегло.
Е250
Този консервант се изпозлва в проиводството на сушени и пушени меса – като цяло в колбасите. Именно на него се дължи характерния за всички розово-червен цвят. Десетки изследвания направени върху този консервант, сочат, че той е канцерогенен, особено след термична обработка. Поради тази причиниа се препоръчва да се избягва прекомерната консумация на продукти от типа на колбасите, съдържащи Е250.
Е282
За консервирането на месни изделия често се използва Е282. Тази хранителна добавка има за цел да предпази продукта от разваляне вследстие образуване на мухъл, плесен и развитие на бактерии. Ако се натурпа в организма, Е282 предизвиква главоболие.
Как можем да се предпазим от консервантите?
За да избегнем консервантите в храните си, е необходимо да следваме няколко прости правила:
- Да сме запознати с вредните консерванти и да следим за тяхното наличие в храната.
- При възможност да пазаруваме от малки поризводители, в чието качество сме сигурни.
- Да търсим храни, които са консервирани с естествени добавки.
- Избягвайте пакетираните храни.
- Търсете алтернативи на любимите си снаксове и захарни изделия, които можете да приготвите вкъщи и да знаете какво точно сте сложили вътре.
- Отглеждайте си сами част от храните, които консумирате. Ако живеете в апартамент, можете към украсата на дома да добавите саксия с билки.
В заключение
Консервантите са добавки в храните, които имат за цел да направят продуктите по-примамливи и по-устойчиви във времето, но те често са опасни за нашето здраве. Познаването им от всеки от нас е от изключителна важност. Всеки от нас трябва да се стреми да намали консумацията на храни, съдържащи консерванти в ежедневието си. Това обаче не означава, че трябва да се вглъбяваме до болка в тези неща. Умереността е ключова във всеки един аспект от живота ни.










Вашият коментар